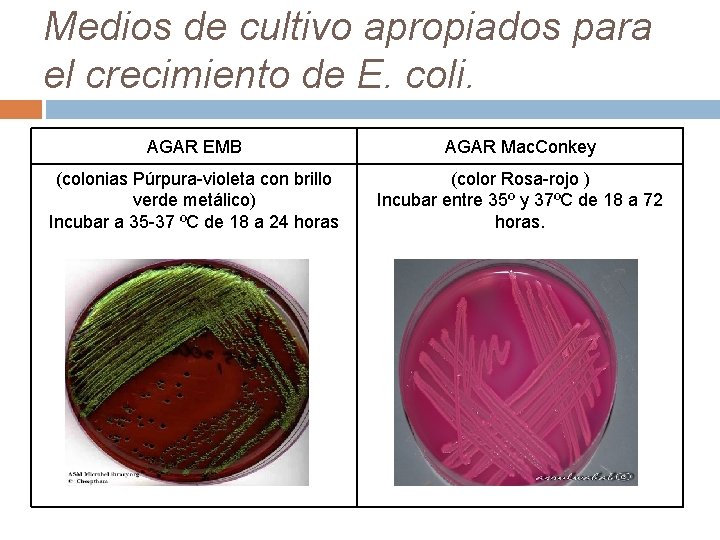
Medios de cultivo apropiados para el crecimiento de E. coli. AGAR EMB AGAR Mac.
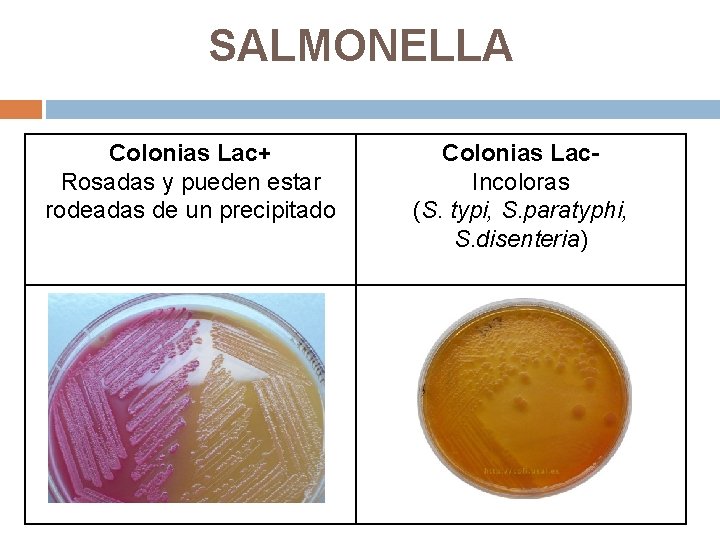
SALMONELLA Colonias Lac+ Rosadas y pueden estar rodeadas de un precipitado Colonias Lac. Incoloras

COPROCULTIVO Instituto Politcnico Nacional Centro de Estudios Cientficos

- Slides: 41
COPROCULTIVO Instituto Politécnico Nacional Centro de Estudios Científicos y Tecnológicos No. 6 “Miguel Othón de Mendizábal” BACTERIOLOGIA Integrantes: • Alvárez Bonifacio Yeredid • Bello Reyes Saúl Joshafat • García Salinas Karen • Martínez Hernández Daniel • Mayen Bernal Viridiana • Quintero Andrés Fabiola Janet • Rosales Hernández Diana Carolina • Sandoval Rosas Eduardo G: 4101 C Profesor: Miguel Ángel Morales Gil Fecha: 09 – Mayo - 2012
Importancia clínica. El médico, frente a un paciente que acude por presentar un cuadro diarreico, debe decidir cuál es la posible etiología y qué tipo de tratamiento debe dar, por lo que recurre al laboratorio a fin de obtener un diagnóstico microbiológico que permita realizar un abordaje racional de la enfermedad.
Diagrama de flujo para el diagnóstico de infecciones gastrointestinales. Materia Agua peptonada TCBS Seleccionar colonias amarillas y sembrar en TSI, LIA, MIO, caldo peptonado y arginina Reacción de aglutinación con suero anti Vibrio cholerae O 1 Campy-Bap Seleccionar colonias y sembrar en TSI, Hacer pruebas de acetato de plomo y de hidrólisis de hipurato Campylobacter Mc. Conkey o EMB Seleccionar colonias y sembrar TSI, LIA y MIO Reacciones de aglutinación con sueros anti A, B, C y D de Shigella Escherichia coli Tipificar con antisueros Yersinia fecal Caldo tetrationato Pruebas rápidas Tinción de Kinyoun Coproparistoscópico Sulfito de bismuto, SS ó Verde Brillante Seleccionar colonias y sembrar en TSI, LIA y MIO Tipificación de Salmonella con sueros anti A, B, C 1, C 2, D y E Identificación de Coccidias Detección de Rotavirus Identificación de quistes de protozoarios , huevecillos y larvas de helmintos Adaptado de: Diagnóstico de Laboratorio de infecciones gastrointestinales. INDRE pp 205
AFECCIONES GASTROINTESTINALES • • La ingestión de patógenos causa muchas infecciones. Los términos utilizados más comúnmente para describir las enfermedades del tracto gastrointestinal son: Diarrea. Disentería.
DIVERSOS SINDROMES DIARREICOS • • • Diarrea aguda liquida Diarrea crónica/ Mal absorción. Gastritis o atrofia gástrica. Diarrea con sangre Fiebre entérica.
¿QUE ES EL COPROCULTIVO? El coprocultivo (cultivo de heces), es un estudio cuyo propósito es buscar bacterias patógenas que causan un daño en el tracto intestinal. Este estudio permite aislar e identificar al agente causal de estas enfermedades.
MECANISMOS QUE CAUSAN LA DIARREA 1)Toxinas 2) Invasión 3) Penetración de la pared intestinal
SINTOMATOLOGIA Algunos síntomas que los pacientes con enfermedades infecciosas a menudo experimentan son: q. FIEBRE q DESHIDRATACION q LETARGO
Toma de muestra Para efectuar un coprocultivo pueden utilizarse las siguientes muestras: • Heces frescas • Hisopo rectal Indicaciones para el paciente: üNo es necesario el ayuno. üNo se requiere dieta especial üNo estar bajo tratamiento con antibióticos o tener más de 72 hrs de haber concluido el tratamiento. En caso de no ser posible ninguna de estas dos opciones, eespecificar en la solicitud del estudio que antibiótico se están tomando y cuantos días lleva haciéndolo.
Indicaciones para la toma y condiciones de la muestra üLa toma de muestra se deberá realizar lo antes posible luego del comienzo de la enfermedad (preferiblemente dentro de los cuatro primeros días). üLa recolección se efectúa en un recipiente de boca ancha estéril y con tapa de rosca. üLas muestras de consistencia formada deberán ser de 4 -6 gramos (tamaño de una nuez), en caso de ser liquidas entre 5 y 1 O ml. üDebe evitarse la contaminación con orina. üSi no se pueden enviar las muestras de manera inmediata se pueden refrigerar sin exceder 4 hrs. ya que a medida que la muestra fecal se enfría, la caída de p. H llega a ser suficiente para inhibir el crecimiento de muchas especies Shigella y algunas de Salmonella.
üLas muestras deben examinarse y cultivarse lo antes posible después de la recolección, si el cultivo se hace dentro de las dos horas después de tomada la muestra, no se requiere medio de transporte, pasado este periodo se recomienda usar el medio de transporte Cary & Blair, caldo selenito o Tioglicolato. üEn general no se recomienda el uso de hisopados rectales pero pueden ser necesarios para obtener muestras fecales de neonatos o adultos mayores. üEl hisopo rectal debe insertarse exactamente más allá del esfínter rectal, evitando el contacto directo con materia fecal en el recto. Estos hisopados deben inocularse de inmediato en medios de cultivo o colocarse en un sistema de transporte adecuado para impedir el desecamiento. üEn pacientes en edad pediátrica que usan pañales las muestras deben ser tomadas preferentemente de sus glúteos y no del pañal seleccionando las partes mucosas, purulentas y/o sanguinolentas y colocarlas en frasco estéril.
EXAMEN MACROSCÓPICO Consistencia (solidas, diarreicas, liquidas) Color; indica la abundancia y la calidad del flujo biliar. Presencia de sangre, pus, moco. Fragmentos de tejidos o restos alimenticios sin digerir Olor
BACTERIAS CAUSANTES DE LA DIARREA
ESCHERICHIA COLI • • • Esta bacteria ha sido incriminada en enfermedades infecciosas que afectan casi cualquier tejido y sistema orgánico humano. Cepas de E. coli que pueden producir gastroenteritis: E. coli enterotoxigenica (ETEC) E. coli enteropatógena (EPEC) E. coli enteroinvasiva (EIEC) E. coli enterohemorrágica (EHEC) E. coli enteroagregante (EAEC) E. coli difusamente adherente (DAEC)
Termino Abreviatura Fenotipo patógeno Signos y síntomas E. coli enterotoxigenica ETEC Elaboración de enterotoxinas termolábiles y/o termoestables secretoras que no dañan el epitelio mucoso Asociado con los sindromas clínicos “diarrea del destete” y “diarrea del viajero”. Tienen inicio brusco típico, casi siempre sin sangre, moco ni pus. La deshidratación y vómitos ocurren en algunos casos. e. coli enteropatógena EPEC Se adhieren a las células epiteliales intestinales en microcolonias localizadas que producen lesiones histopatológicas características conocidas como “lesiones de fijación y desprendimiento” Habitualmente ocurre en lactantes, se caracteriza por fiebre, vómitos, diarrea acuosa con gran cantidad de moco y en algunas ocasiones se observan leucocitos en las heces. E. coli enteroinvasiva EIEC La mayoría de las cepas son inmóviles, fermentadoras tardias o no fermentadoras de la lactosa y anaerogenas. Se presenta principalmente como diarrea acuosa, se tiene necesidad imperiosa de defecar, presencia de moco, sangre y muchos leucocitos en las heces. E. coli enterohemorrágica EHEC Elaboración de toxinas shiga Diarrea sanguinolenta sin leucocitos, dolor abdominal frecuente. E. coli enteroagregante EAEC Se adhieren a las células epiteliales Diarrea con moco, fiebre leve y poco o y producen una toxina (EASTI) nada de vomito. E. coli difusamente adherente DAEC Se adhieren a las células epiteliales Diarrea en la mayoría de las veces sin en un patrón difuso presencia de sangre ni leucocitos
Medios de cultivo apropiados para el crecimiento de E. coli. AGAR EMB AGAR Mac. Conkey (colonias Púrpura-violeta con brillo verde metálico) Incubar a 35 -37 ºC de 18 a 24 horas (color Rosa-rojo ) Incubar entre 35º y 37ºC de 18 a 72 horas.
SHIGELLA Shigella es un bacilo gram negativo perteneciente a la familia Enterobacteriaceae, que se encuentra estrechamente relacionada con el genero Escherichia, por sus propiedades bioquímicas, serológicas y por similitudes genéticas.
SS, Agar Las colonias sospechosas de Shigella crecidas en Agar. Salmonella. Shigella son transparentes, translúcidas u opacas y suelen ser lisas. En este medio las colonias de otros microorganismos que fermentan la lactosa (coliformes) son colonias rojizas y en muchos casos mucoides.
Sulfito Bismuto Agar Sembrar por estría el material objeto de estudio o el procedente del caldo de enriquecimiento en este caso con caldo tetrationato. Incubar a 35± 2ºC de 24 a 48 horas. Shigella flexneri ATCC 12022 Crecimiento (Nuloescaso) Color ( Marrón)
SALMONELLA Colonias Lac+ Rosadas y pueden estar rodeadas de un precipitado Colonias Lac. Incoloras (S. typi, S. paratyphi, S. disenteria)
Agar SS No fermentadoras de lactosa (colonias incoloras). Presentan colonias con centro negro. (productoras de Acido sulfúrico)
Agar Verde Brillante Colonias de color rosa a blanco, opacas rodeadas por el rojo brillante del medio
Agar EMB Las colonias de Salmonella y Shigella son translúcidas, de color ámbar o incoloras.
VIBRIO Es un bacilo Gram (-) curvo que posee un flagelo polar produce oxidasa y fermenta glucosa.
GASTROENTERITIS V. Cholerae es el prototipo de los síndromes diarreicos causados por la producción de toxinas coléricas.
Aislamiento en el Laboratorio Clínico Enriquecimiento de la muestra: Agua peptonada Alcalina, p. H 9. 0, de 6 -8 horas a 37° C Sembrado: Medio de cultivo TCBS, mantener a 37°C y revisar entre las 18 -24 horas. Seleccionar colonias de color amarillo para Vibrio Cholerae
V. Cholerae en medio TCBS
Vibrios no coléricos Además de V. Cholerae existen otras especies de vibrios como: V. Parahemolyticus V. Mimicus V. Metschnikovil V. Hollisae V. Furnisae V. Fluviales
Yersinia • • Son las responsables de algunas afecciones como gastroenteritis, diarrea y linfadenitis mesentérica. Las bacterias patógenas de la Yersinia son: Y. enterocolitica Y. pseudotuberculosis Y. enterocolitica en Agar Mac. Conkey Las colonias tienden a ser puntiformes después de 24 horas
CAMPILOBACTER Morfología y características: Se trata de bacterias gram negativas, pequeñas (0. 3 -0. 6 μm de diámetro, 0. 5 -5 μm de ancho), no esporuladas, con una forma distintiva curva o en espiral, con aspecto de vibrio, cuando se observan a partir de cultivos jóvenes; con más de 48 horas de incubación o tras prolongada exposición al aire adoptan una forma cocoide.
Los Medios más usados para su aislamiento son Skirrow, Butzler y Campy-BAP. Las colonias pueden apreciarse en las placas en 24 -48 horas. Campylobacter jejuni Medio Butzler
IDENTIFICACION HASTA ESPECIE La identificación hasta especie se realiza a partir de pruebas bioquímicas. Para las bacterias que se encuentran en el coprocultivo normalmente estas pruebas se realizan con los siguientes medios de cultivo: • TSI • LIA • MIO • Citrato de sodio • Urea • Agar Hierro de Kligler (La lectura e interpretación de las mismas se explican en los anexos correspondientes. )
Identificación Final Antisueros: Suero que contiene anticuerpos (inmunoglobulinas) específicos frente a un determinado antígeno o a varios o Suero animal o humano que contiene anticuerpos contra una enfermedad específica, que se utilizan para proporcionar inmunidad pasiva frente a dicha enfermedad. Los antisueros no dan lugar a la producción de anticuerpos. Anticuerpo: Molécula de inmunoglobulina específica de antígeno, producida por un clon de linfocitos B en respuesta a su estimulación por dicho antígeno concreto. Antígeno: Es una sustancia que se combinará con un anticuerpo a raves de sitios de unión específicos. Sustancia capaz de reaccionar con las moléculas específicas propias de una respuesta inmunitaria, es decir, anticuerpos y receptores de linfocitos T.
Identificación Final El método tradicional para preparar antisueros ah sido inyectar el antígeno en un animal (cordero, conejo, caballo, cuyo, cabras, etc…). El animal genera entonces anticuerpos. Los antisueros se inyectan a los animales para que estos se pongan en contacto con las bacterias y se generen anticuerpos (específicos para las bacterias que se inocularon en los animales). Posteriormente estos anticuerpos se extraen de la sangre de los animales para ser utilizadas en la identificación de bacterias aisladas de muestras biológicas. Cuando hay formación de precipitados da positivo a la bacteria estudiada.
ANTIBIOGRAMA DEL COPROCULTIVO En caso de encontrar algún agente patógeno es necesario realizar un antibiograma por el método de Bauer-Kirby.
POR SU ATENCIÓN, ¡GRACIAS! : D